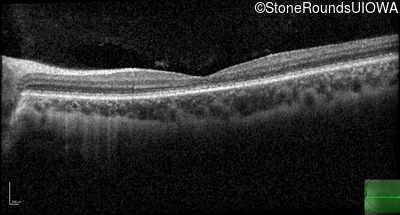
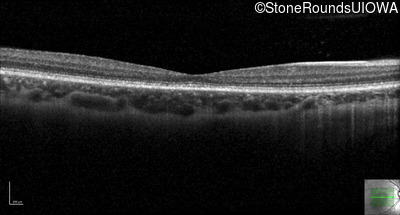
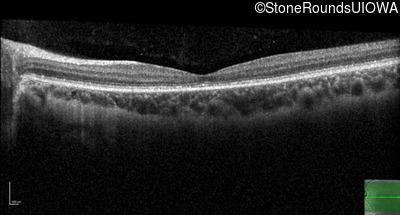

Case
SR2660
Student Mode
Cone and Cone Rod Dystrophy (IA1b)
Female
Female
Hidden
SR2660
Student Mode
Cone and Cone Rod Dystrophy (IA1b)
Female
Female
Highlighted Images
| Age at visit: 16 years | OD | OS |
|---|---|
History
This 16-year-old female complains of difficulty tracking softballs in flight. Her parents first noticed problems with her vision at age 3 when she would turn slightly away from objects to look at them. There is no family history of vision loss.
| Age at visit: 16 years |
| OD | OS | ||
|---|---|---|---|
| OD | OS | ||
|---|---|---|---|
| OD | OS | ||
|---|---|---|---|
Diagnosis & molecular findings
| Disease | Gene | Allele 1 variant(s) | Allele 2 variant(s) | Inheritance mode |
|---|---|---|---|---|
| Cone and Cone Rod Dystrophy | GUCY2D | Arg838Cys CGC>TGC | AD |
Disease:
Gene:
Allele 1:
Arg838Cys CGC>TGC
Allele 2:
Inheritance:
AD